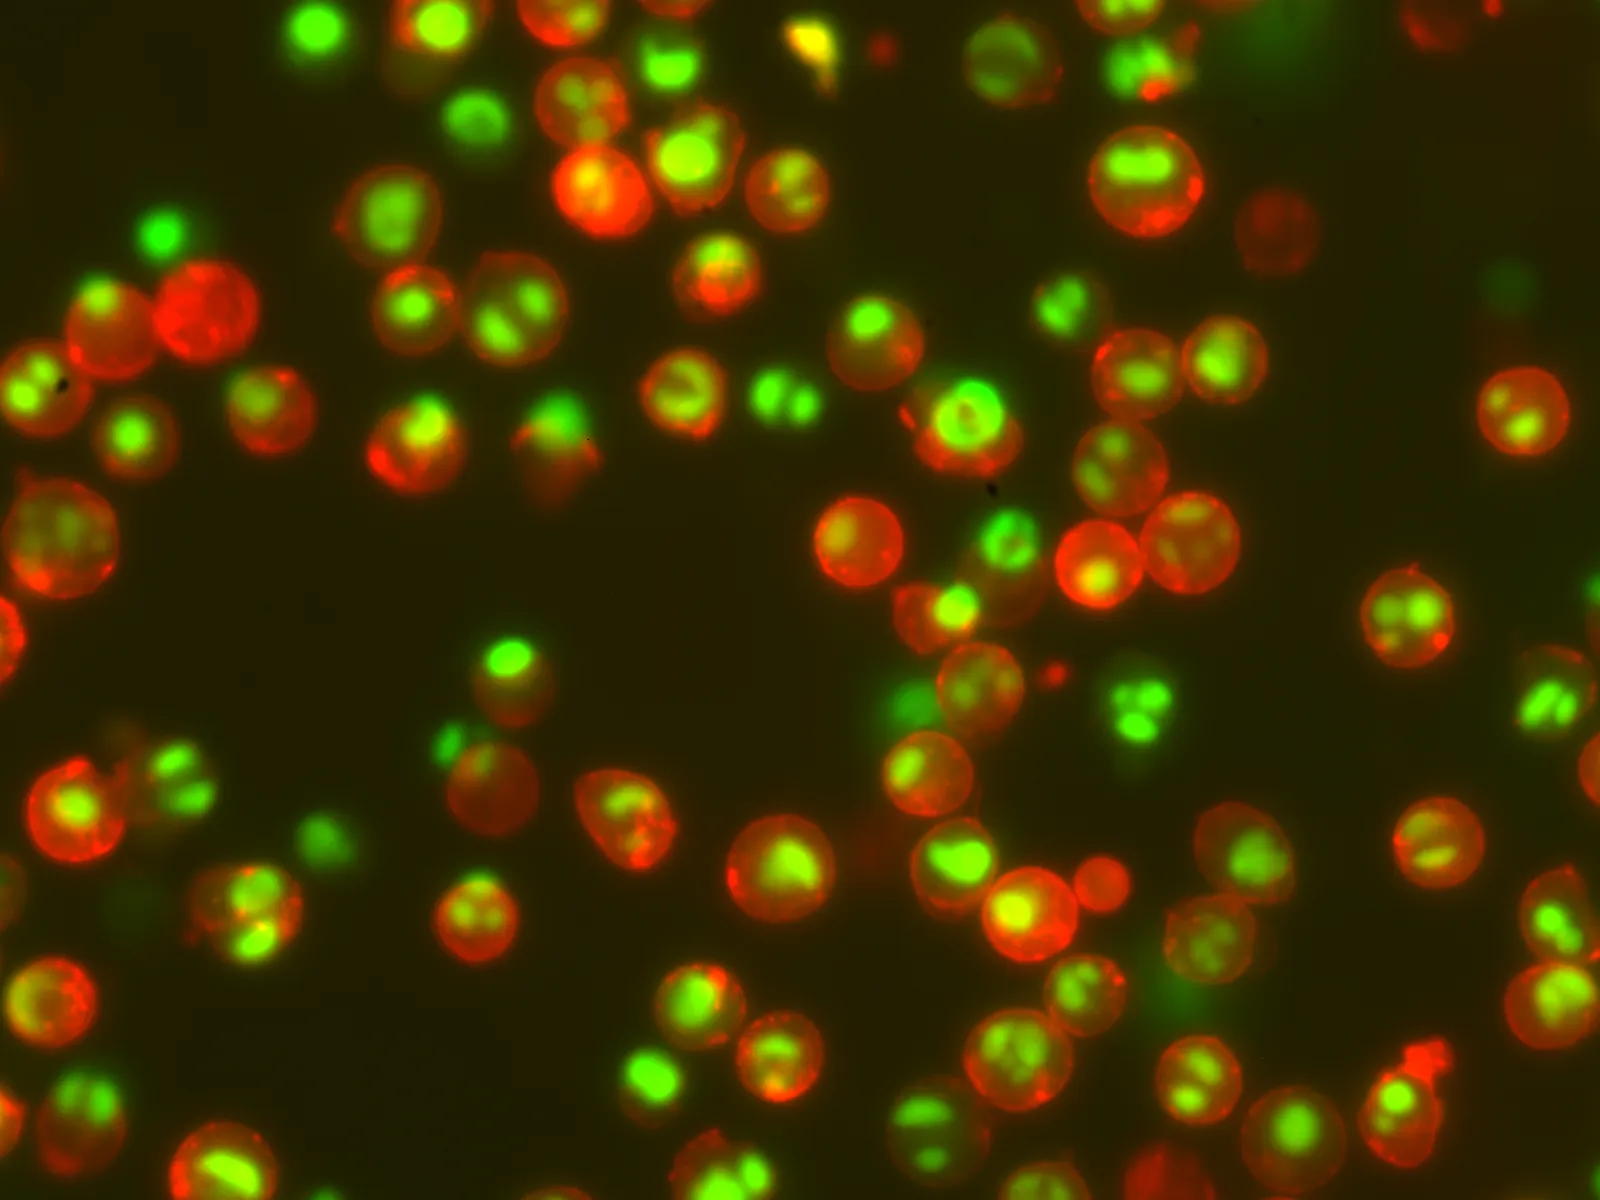
NucView® 530 Caspase-3 Substrate, 1 mM in DMSO, Trial Size - image 3

NucView® 530 Caspase-3 Substrate, 1 mM in DMSO, Trial Size
CAT:
37-10406-T
Size:
10 µL
Price:
Ask
- Availability: 24/48H Stock Items & 2 to 6 Weeks non Stock Items.
- Dry Ice Shipment: No

NucView® 530 Caspase-3 Substrate, 1 mM in DMSO, Trial Size
Description:
NucView 530 Caspase-3 Substrate, 1 mM in DMSO, provides a convenient tool for detecting caspase activity in intact cells in real time by either fluorescence microscopy or flow cytometry; the substrate stains apoptotic cell nuclei with orange fluorescence (Ex/Em 528/563 nm).UNSPSC:
41116113UNSPSC Description:
Cytology reagents or solutions or stainsSource:
SyntheticStorage Conditions:
4°C; Protect from lightShelf Life:
6 months
DATASHEET Document
View DocumentMSDS Document
View Document